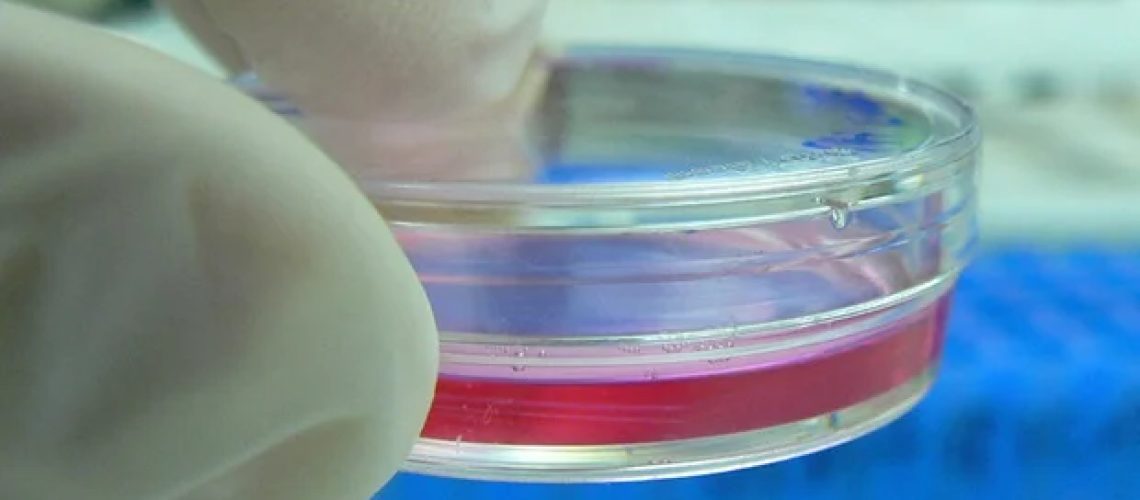
שכבות תאי מזנכימלי ואנדותל מהונדסים מחקים ביעילות בלוטות לימפה מקומיות

השכיחות העולה של סרטן ברחבי העולם הובילה למספר הולך וגדל של ניתוחים הכוללים הסרה של בלוטות לימפה. למרות שלהליכים אלה יש תפקיד מרכזי בבימוי הסרטן ובמניעת התפשטות של מחלות ממאירות, הם מגיעים לפעמים עם השלכות קשות לטווח ארוך. מכיוון שבלוטות הלימפה אינן מתחדשות באופן טבעי לאחר הסרתן, היעדרן עלול להוביל למצב המכונה לימפדמה משנית. זה מתבטא בנפיחות כרונית, אי נוחות וניידות מופחתת בגפיים או באזורים שנפגעו, ופוגעים קשות באיכות החיים של המטופל.
כתוצאה מכך, מוקד עיקרי בתחום הרפואה הרגנרטיבית הוא פיתוח אסטרטגיות לשיקום או חידוש מבנים לימפתיים פגומים כדי לטפל ביעילות בבצקת לימפה משנית. הגישות הקיימות התרכזו במידה רבה בתאי גזע והשתלת רקמות לימפה. עם זאת, טכניקות אלו דורשות לעתים קרובות פרוטוקולי הכנה מורכבים, וחשוב מכך, הוכיחו יעילות מוגבלת בשיפור הסימפטומים הקליניים העיקריים של בצקת לימפה.
על רקע זה, צוות מחקר בראשות פרופסור-משנה קוסוקה קוסמורי מהפקולטה למדעי התרופות באוניברסיטת טוקיו למדע (TUS), יפן, הוא חלוץ בטכניקה חדשנית להנדסת רקמות לימפה שיכולה לחולל מהפכה בטיפול בבצקת לימפה משנית. המחקר שלהם, שפורסם בכרך 16 של כתב העת תקשורת טבע ב-19 בנובמבר 2025, מתאר פרוטוקול פשוט לייצור רקמות לימפה מהונדסים ביו-הנדסיים שיכולים לשחזר את זרימת הלימפה לאחר הסרת בלוטות הלימפה. עבודה זו נכתבה על ידי דוקטורנט שנה ב' מר שו אובנה, עוזר פרופסור שוקו איטאקורה ופרופסור מאקיה נישקאווה, אף הם מ-TUS.
הגישה המוצעת מבוססת על טכניקת ערימת תאים צנטריפוגליים חדשה להנדסת רקמה חלופית עבור בלוטות לימפה שהוסרו בניתוח. ראשית, החוקרים הציבו תאי גזע מזנכימליים (MSCs), אשר ידועים כתומכים בהתחדשות רקמות ומספקים פיגומים מבניים, בבארות של צלחת תרבית Transwell. על ידי צנטריפוגה של הצלחת כולה, MSCs התיישבו באופן אחיד בתחתית הבארות, ויצרו שכבה ראשונה. לאחר מכן, החוקרים הוסיפו תאי אנדותל לימפה לבארות, ולאחר מכן סבב נוסף של צנטריפוגה כדי לפזר אותם באופן שווה כשכבה שנייה. לבסוף, לאחר שלב צנטריפוגה אחרון לאחר הוספת MSCs שוב, התוצאה הייתה מבנה תאי תלת-שכבתי, אשר החוקרים כינו רקמה לימפטית מבוססת צנטריפוגה (CeLyT).
בעזרת מודל של חיה לימפתית, הצוות שיקם בלוטות לימפה פונקציונליות שהפגינו דמיון מבני עם בלוטת לימפה מקומית. הם אישרו כי השתלת CelyTs החזירה את זרימת הלימפה בעכברים אשר בלוטות הלימפה הפופליטאלי והמפשעתי שלהם בגפה התחתונה הימנית הוסרו. כתוצאה מכך, עכברים אלה הפגינו שיפור יוצא דופן בתסמיני בצקת לימפה, כאשר עובי כפותיהם ורגליהם חזר לקדמותו תוך מספר שבועות. בנוסף, עכברים שקיבלו CeLyTs הראו גם התאוששות של יכולת הסינון ואוכלוסיות תאי חיסון כגון תאי T ומקרופאגים, והצטברות נמוכה יותר של רקמת שומן באזורים הפגועים, והגיעו לרמות דומות לעכברים רגילים.
החוקרים ניתחו בקפידה את המבנים שנוצרו לאחר השתלת CeLyT כדי לשפוך אור על ההשפעות הטיפוליות שנצפו. "CelyTs עשויים לגרום תחילה להיווצרות לימפה וכלי דם סביב מקום ההשתלה, מה שמוביל להקמת מבנה דמוי בלוטות לימפה לא בוגר הנוצר על ידי שילוב תאים שמקורם מארח ברקמה בתוך מספר ימים, ולאחר מכן הבשלתו ויכולתו לתפקד כצומת לימפה תוך 10 ימים לאחר ההשתלה.," מסביר ד"ר קוסמורי.
מחקר זה מציין את ההתחדשות המוצלחת הראשונה בעולם של בלוטות לימפה מתפקדות במלואן באמצעות השתלת תאים, ומציע אפשרות טיפולית מבטיחה לחולים המפתחים בצקת לימפה, בעקבות ניתוחים אונקולוגיים הכוללים דיסקציה של בלוטות הלימפה. מבחינה כלכלית, השתלה בודדת יכולה לספק יתרונות טיפוליים ארוכי טווח, ולהפחית באופן משמעותי את העלויות המצטברות הקשורות לביקורים חוזרים בבית החולים ושימוש ארוך טווח בבגדי דחיסה. בסך הכל, תוצאות אלו מדגישות את הפוטנציאל המרפא החזק של החדרת רקמה מהונדסת ביולוגית מתאימה למערכת הלימפה, ועולה על היעילות של אפשרויות הטיפול הנוכחיות לבצקת לימפה.
"למרות שטיפול דחיסה מייצג את תקן הזהב לטיפול בלימפדמה בפרקטיקה הקלינית, הוא בדרך כלל מעכב את הנפיחות בכפותיהם של עכברי לימפדמה. לעומת זאת, CeLyTs היו יעילים יותר בדיכוי בצקת לימפה, והפגינו גם השפעות טיפוליות חזקות אפילו במודל לימפדמה כרונית חמורה יותר.", מעיר ד"ר קוסמורי.
יתרה מכך, CeLyTs הדגימו אפקט דיכוי לימפדמה גדול יותר, בהשוואה לרקמות ביולוגיות שיוצרו בשיטות הנדסת רקמות אחרות."
Kosuke Kusamori, פרופסור חבר, הפקולטה למדעי התרופות, אוניברסיטת טוקיו למדע
בואו נקווה ש-CeLyTs יתורגמו לפרקטיקה קלינית!